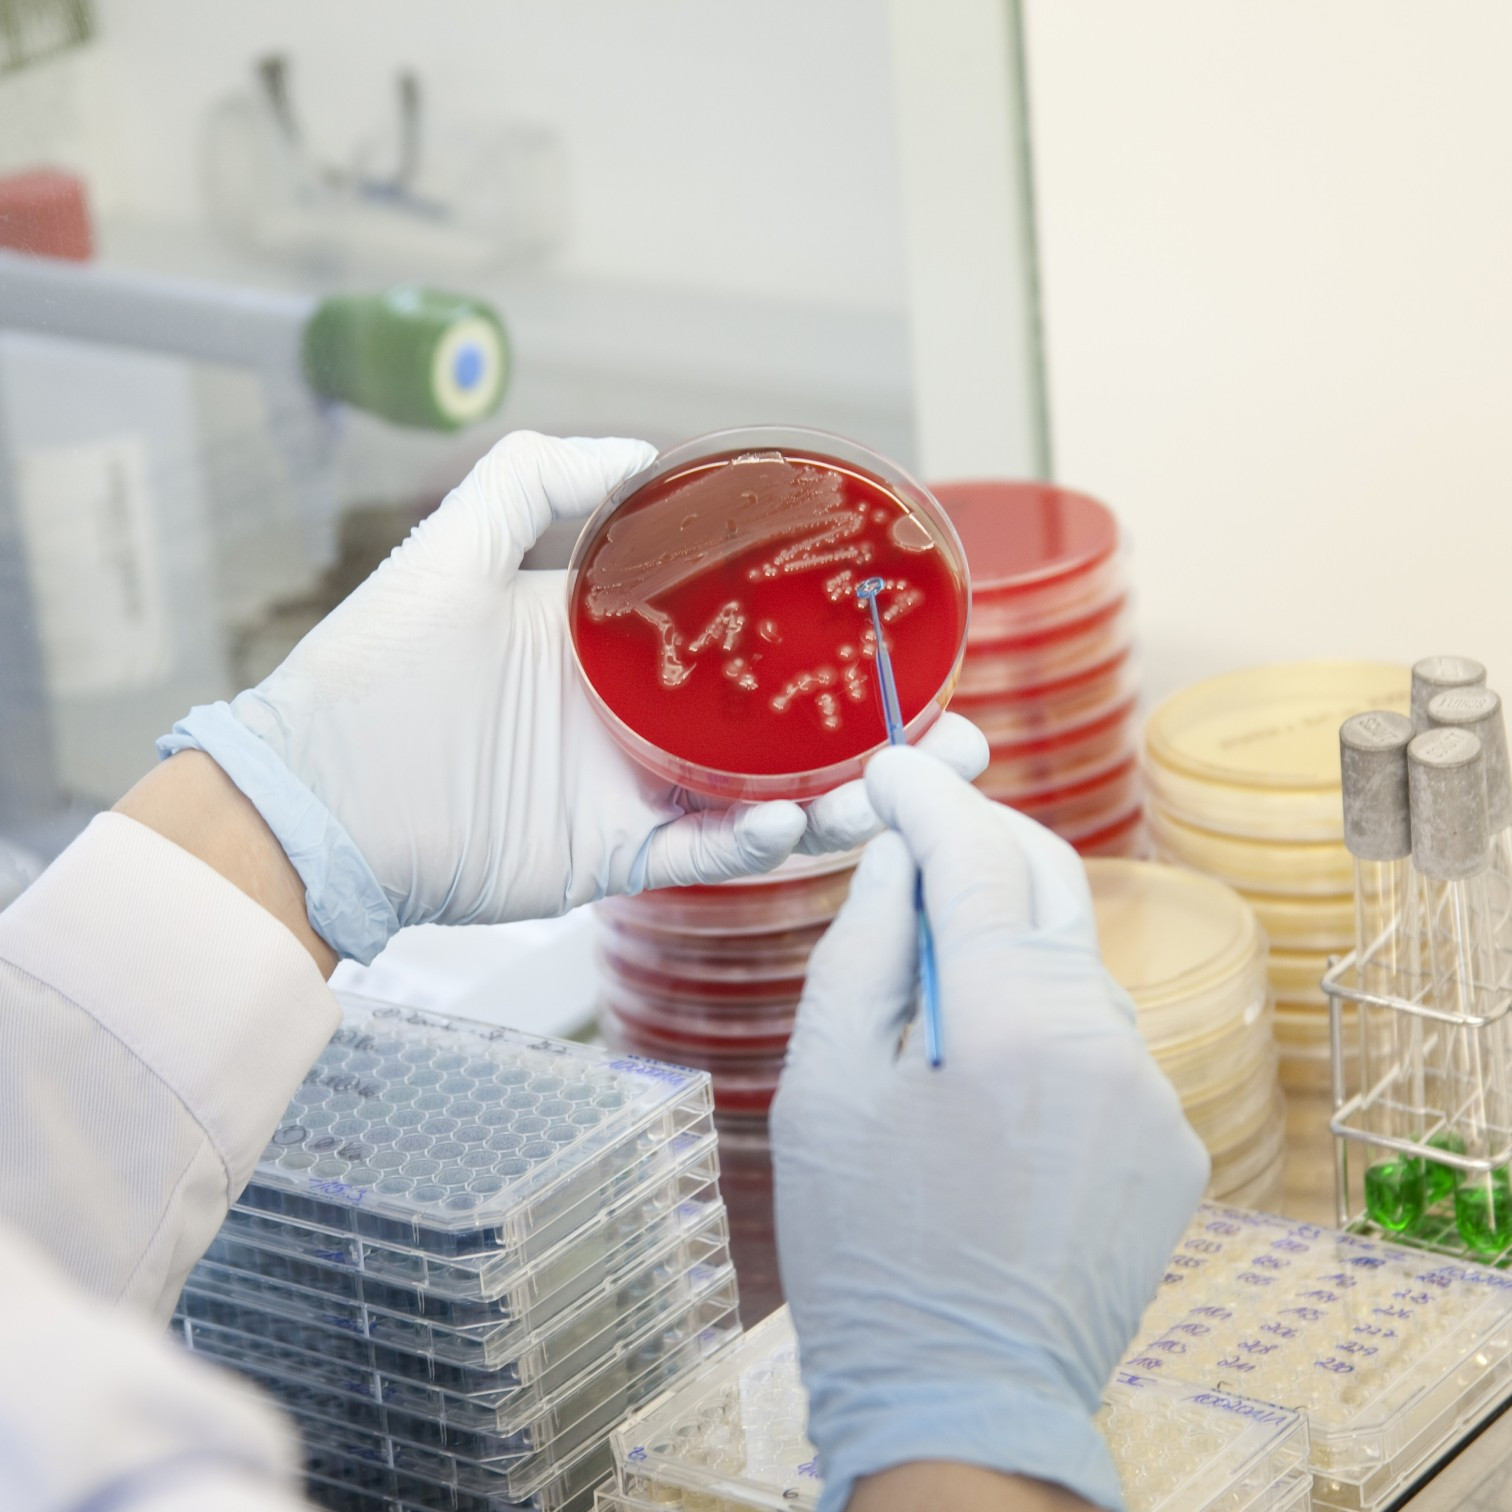
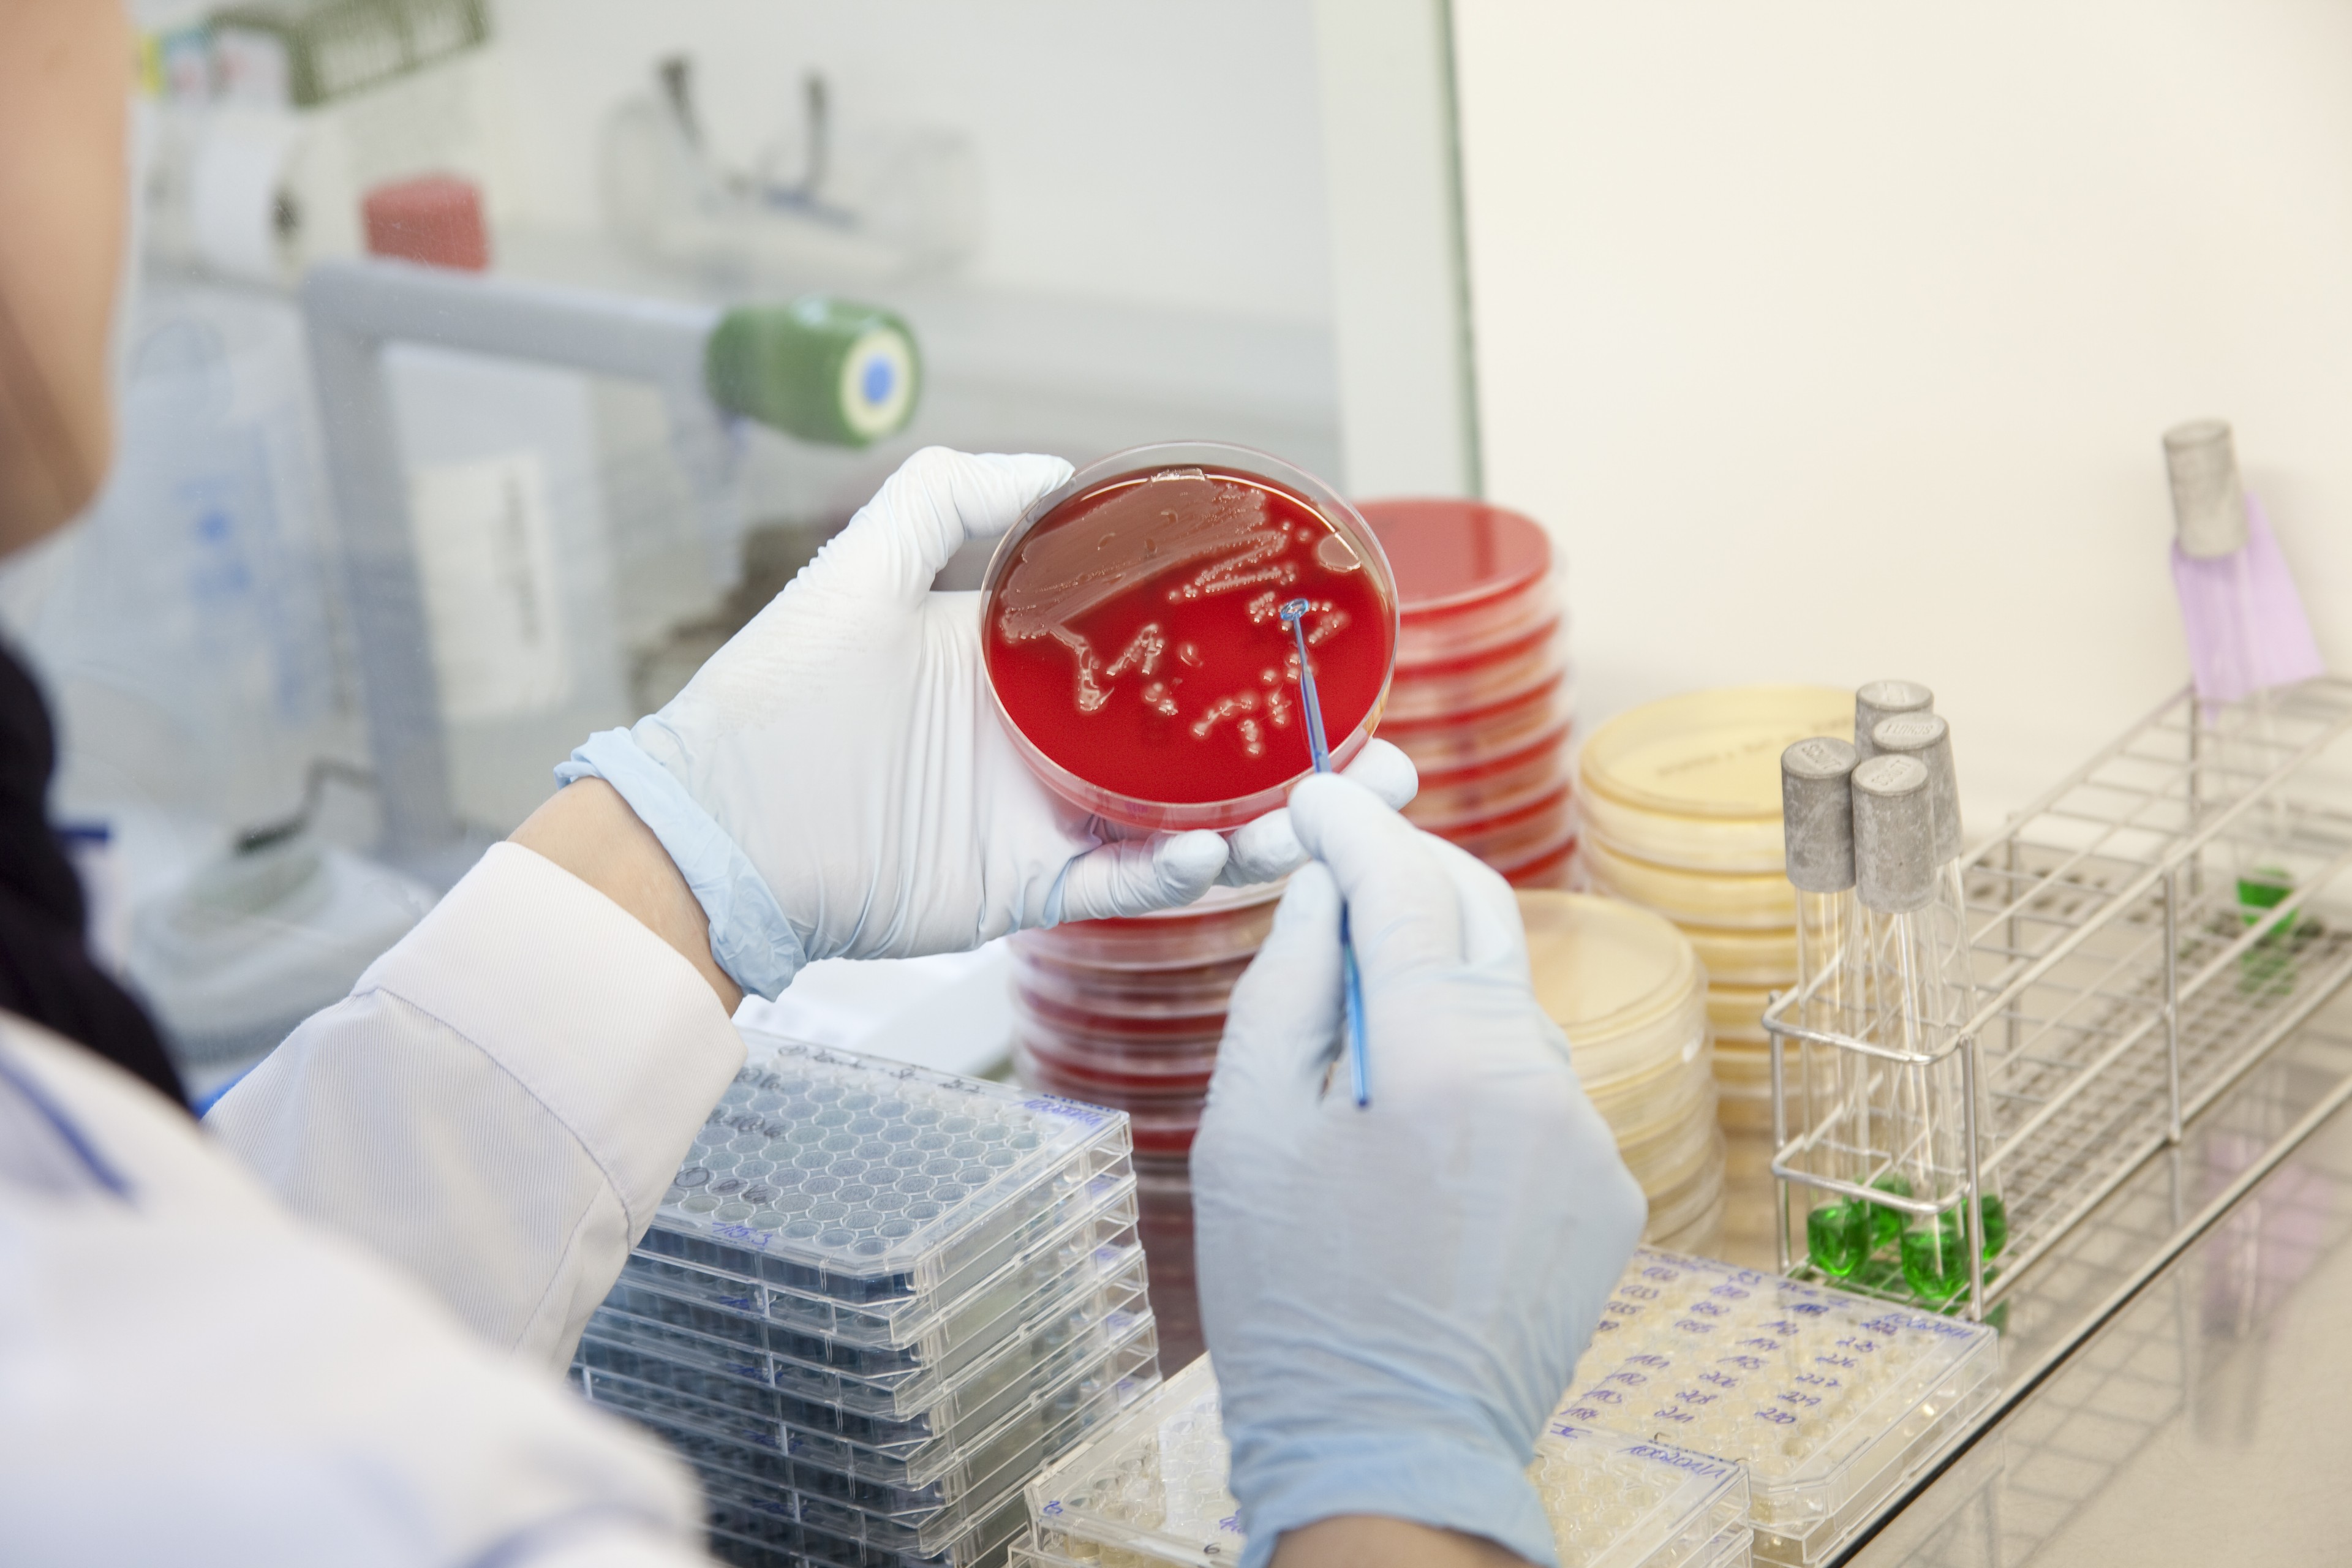

Institut für Mikroökologie - Die Spezialisten für Mikrobiom, Schleimhaut, Allergien und Unverträglichkeiten
Im MVZ Institut für Mikroökologie arbeiten die Spezialisten für Erkrankungen, an deren Entstehung Veränderungen von Mikrobiom und Schleimhaut beteiligt sind.

Fast 70 Jahre Mikrobiota-Diagnostik
Auf einen Erfahrungsschatz von fast 70 Jahren greift das MVZ Institut für Mikroökologie heute zurück. Wir untersuchen Schlüsselbakterien auf und in unserem Körper – mit den Schwerpunkten Darmmikrobiota, Vaginalmikrobiota und Mundflora.
Die Darmmikrobiota-Analysen rücken immer weiter in den Fokus der Wissenschaft; heute beschäftigt sich die Mikrobiomforschung weltweit mit dem Thema. Wissenschaftler sind sich mittlerweile darüber einig, wovon vor sieben Jahrzehnten zwei junge Ärzte in einem kleinen mikrobiologischen Labor in Herborn ausgingen: Zwischen Darmbakterien und vielen Krankheiten besteht ein direkter Zusammenhang. Die Herborner Pioniere betrachteten den Menschen schon damals ganzheitlich und in Symbiose mit den ihn besiedelnden Mikroben. Die Darmmikrobiota-Diagnostik gab ihrer Ansicht nach Aufschluss über ein gestörtes Zusammenspiel von Mensch und Umwelt. Heute bestätigt die Mikrobiomforschung den Zusammenhang zwischen chronischen Erkrankungen und einer bakteriellen Dysbiose im Darm; sie bietet uns permanent interessante Möglichkeiten für die Entwicklung neuer, praxistauglicher Mikrobiom-Diagnostiken.
Das Institut für Mikroökologie entwickelt Verfahren auf mikrobiologischer, immunologischer und molekularbiologischer Basis für die Diagnostik der Darmflora und die Analyse der Darmschleimhaut, um den praktischen Arzt bei seiner täglichen Arbeit kompetent zu unterstützen. Dafür überträgt das Institut aktuelle Forschungsergebnisse zur Diagnostik der Mikrobiota und der Darmschleimhaut in gezielte und für den Patienten sinnvolle Nachweismethoden. Eine Zusammenarbeit mit Universitäten unterstützt das innovative Vorgehen und setzt labormedizinisches Arbeiten auf höchstem technischen Niveau voraus.
Youtube inaktiv
Aufgrund Ihrer Cookie-Einstellungen kann dieses Modul nicht geladen werden.
Wenn Sie dieses Modul sehen möchten, passen Sie bitte Ihre Cookie-Einstellungen entsprechend an.


Von A wie Abdominalbeschwerden bis Z wie Zahnerkrankung
Das Institut für Mikroökologie ist nicht nur langjähriger Partner für Ärzte und Therapeuten, Zahnärzte, Hebammen und Apotheker. Seit dem ersten Diagnostikangebot hat das Institut für Mikroökologie ca. 130 labormedizinische Untersuchungen zur Diagnose der Darmmikrobiota, der Mundflora, der Urogenitalmikrobiota, zur Darmschleimhaut- und Allergie-Diagnostik und zur Darmkrebsvorsorge ins Portfolio aufgenommen. Von Abdominalbeschwerden, Allergien, gynäkologischen Erkrankungen, Zahnerkrankungen, Infektionen bis hin zu Vorsorgemaßnahmen – das Angebot unserer labormedizinischen Verfahren ist breit aufgestellt.
Unser hochmodernes Labor ermöglicht eine schnelle und umfassende Diagnostik der Mikrobiota und Schleimhaut und gibt dem Arzt fundierte Therapieempfehlungen bestehend aus naturheilkundlichen und schulmedizinischen Ansätzen. Anschauliche Seminare liefern Informationen, welche diagnostischen Verfahren indikationsbezogene Aussagen über Mikrobiota und Schleimhaut liefern und so verhelfen, die Ursachen chronischer Erkrankungen aufzuspüren.
Der Fachbereich Labordiagnostik des MVZ Institut für Mikroökologie ist ein durch die DAkkS nach DIN EN ISO 15189 akkreditiertes Medizinisches Laboratorium. Die Akkreditierung gilt nur für den in der Urkundenanlage (D-ML-13337-01-00) aufgeführten Akkreditierungsumfang (Liste der akkreditierten Verfahren).



